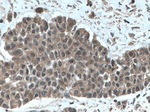
TRIM21 Antibody in Immunohistochemistry (Paraffin) (IHC (P))

Search
Proteintech
TRIM21 Polyclonal Antibody
{{$productOrderCtrl.translations['antibody.pdp.commerceCard.promotion.promotions']}}
{{$productOrderCtrl.translations['antibody.pdp.commerceCard.promotion.viewpromo']}}
{{$productOrderCtrl.translations['antibody.pdp.commerceCard.promotion.promocode']}}: {{promo.promoCode}} {{promo.promoTitle}} {{promo.promoDescription}}. {{$productOrderCtrl.translations['antibody.pdp.commerceCard.promotion.learnmore']}}

Please note: We are reviewing Western blot images included in the antibody testing data in our catalog, including those provided by third parties. Unless expressly labeled or annotated as “raw-unedited”, Western blot images included in the antibody testing data in our catalog may have been edited, optimized or otherwise adjusted for presentation.
产品信息
12108-1-AP
种属反应
已发表种属
宿主/亚型
分类
类型
抗原
偶联物
形式
浓度
规格
纯化类型
保存液
内含物
保存条件
运输条件
产品详细信息
Immunogen sequence: SRIHAEFVQ QKNFLVEEEQ RQLQELEKDE REQLRILGEK EAKLAQQSQA LQELISELDR RCHSSALELL QEVIIVLERS ESWNLKDLDI TSPELRSVCH VPGLKKMLRT CAVHITLDPD TANPWLILSE DRRQVRLGDT QQSIPGNEER FDSYPMVLGA QHFHSGKHYW EVDVTGKEAW DLGVCRDSVR RKGHFLLSSK SGFWTIWLWN KQKYEAGTYP QTPLHLQVPP CQVGIFLDYE AGMVSFYNIT DHGSLIYSFS ECAFTGPLRP FFSPGFNDGG KNTAPLTLCP LNIGSQGSTD Y (176-475 aa encoded by BC010861)
靶标信息
This gene encodes a member of the tripartite motif (TRIM) family. The TRIM motif includes three zinc-binding domains, a RING, a B-box type 1 and a B-box type 2, and a coiled-coil region. The encoded protein is part of the RoSSA ribonucleoprotein, which includes a single polypeptide and one of four small RNA molecules. The RoSSA particle localizes to both the cytoplasm and the nucleus. RoSSA interacts with autoantigens in patients with Sjogren syndrome and systemic lupus erythematosus. Alternatively spliced transcript variants for this gene have been described but the full-length nature of only one has been determined.
仅用于科研。不用于诊断过程。未经明确授权不得转售。
生物信息学
蛋白别名: 52 kDa ribonucleoprotein autoantigen Ro/SS-A; 52 kDa Ro protein; 52kD Ro/SSA autoantigen; E3 ubiquitin-protein ligase TRIM21; ro(SS-A); sjoegren syndrome type A antigen; Sjogren syndrome antigen A1; SS-A; tripartite motif protein 21; tripartite motif-containing protein 21
基因别名: Ro52; Ssa1
Entrez Gene ID: (Mouse) 20821




